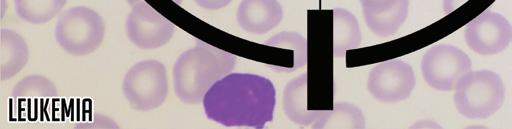

LETTER FROM OUR FOUNDER
Welcome to Central Oregon Gives 2025!
We’re thrilled to celebrate our eighth year of supporting local nonprofits through this community-driven, year-end digital giving campaign. Nothing inspires generosity like the amazing gifts our sponsors have provided for everyone who donates to their favorite nonprofit this season. I am very excited that we have even more folks from the community stepping forward to donate than we have in the past making our give back to donors only that more robust!
In today’s challenging funding landscape, many nonprofits continue to innovate while striving to meet community needs amid shifting federal and state funding. As resources tighten, the support of individuals like you becomes more vital than ever.
Every dollar contributed through centraloregongives.com goes directly to the nonprofit you choose. By using stripe, all funds go directly to the non-profit without overhead. We extend a heartfelt thank-you to our primary local business supporter First Interstate Bank for going above and beyond to support an entire category again this year. Our team at The Source and Lay It Out Events invest countless hours to ensure each giving season is a success for our nonprofit partners. This is our year-end giving program to the community that supports us the rest of the year.
Last year, together, we raised more than one million dollars for Central Oregon charities — an incredible milestone made possible by you. This year, given the heightened need, let’s make it 1.5 for the people holding the social safety net together.
From all of us to all of you: thank you for your generosity, your spirit, and your commitment to giving. Let’s make this year our biggest yet!
Warmly,
Aaron Switzer, Publisher
The Source Weekly

















BRIGHTER FUTURES FOR YOUTH






























HOMELESSNESS




















HOW TO PARTICIPATE
1. Research nonprofits using this guide or visit centraloregongives.com
2. At centraloregongives.com go to the nonprofit pages of your choice to donate
3. Click the donate now button and use a card to donate
4. For every donation of $25 or more you get the weekly incentive! Give generously!
5. Visit local businesses to redeem your special gifts by Jan. 15, 2026
6. Watch the donations roll in and see who wins the big prize!
SCAN TO VISIT
ABOUT CENTRAL OREGON GIVES
Central Oregon Gives is not just an annual giving program; it’s a movement that empowers our community to come together and make a real difference. Powered by your favorite free, weekly newspaper, the Source, Central Oregon Gives has consistently raised thousands of dollars each year for local nonprofits. But we need your help to keep the momentum going and continue supporting the causes that matter most to our community.

This year, we’re encouraging families to come together and inspire the next generation by teaching their young kids the importance of giving back. Through the Central Oregon Gives Family Giving initiative, kids and teens will have the opportunity to experience the joy of making a difference in their community, fostering a spirit of generosity and compassion from a young age. Join us in nurturing a culture of philanthropy and community support.
Every donation of $25 or more receives a SPECIAL OFFER from one of our local sponsors.
WEEK 1 - Nov 6-12
Pinky G’s Pizzeria, 3rd Street Beverage & Mt Bachelor
• 1 free slice of pizza from Pinky G’s Pizzeria
• Be entered to win a gift basket from 3rd Street Beverage
• Be entered to win 1 of 4 one day lift tickets to Mt. Bachelor
WEEK 2 - Nov 13-19
Stoller Wine Bar Bend & Evoke Healing Space and Spa
• 1 free Charcuterie Board with visit to Stoller Wine Bar Bend and be entered to win a wine tasting for 4 at Stoller Wine Bar
• Be entered to win a Renewal Retreat Spa Package from Evoke Healing Space and Spa
WEEK 3 - Nov 20-Nov 26
High Desert Frameworks, Metalheads Boutique & Powder House
• 1 free 8x10 print from High Desert Frameworks
• Be entered to win a custom pet tag & matching keychain OR bracelet from Metalheads Boutique
• Be entered to win a kids ski or snowboard season lease at the Powder House
WEEK 4 - Nov 27-Dec 3
Backporch Coffee Roasters & HooDoo Ski Area
• 1 free cup of coffee from Backporch Coffee Roasters (downtown location only)
• Be entered to win a Coffee Lovers Gift Box: 2 bags of coffee and a mug from Backporch Coffee Roasters
• Be entered to win 4 HooDoo Lift Tickets
FOR DONORS 21 AND UNDER!
Our Family Giving Category Sponsor is Mountain Burger. Earn a Free Dirty Soda when you donate.
WEEK 5 – Dec 4-Dec 10
Silver Moon Brewing, Moonfire & Sun Garden Center & Makin’ It Local
• 1 free pint from Silver Moon Brewing
• 1 free plant propogation from Moonfire & Sun Garden Center
• Be entered to win a $25, $50 or $100 Makin’ It Local Gift Card
• Be entered to win 1 of 2 $100 gift cards to Moonfire&Sun Garden Center
WEEK 6 - Dec 11-Dec 17
Cascade Lakes Brewing Co, Teacupfuls, Snow Dermatology, & Hawkeye & Huckleberry Lounge
• 1 free pint and be entered to win a $50 gift card Cascade Lakes Brewing Co (valid at Reed Market or Redmond location)
• Be entered to win a bundle of 5 free drinks from Teacupfuls
• Be entered to win one syringe of Restylane from Snow Dermatology
• Be entered to win a $250 gift card for Hawkeye & Huckleberry Lounge
WEEK 7 – Dec 18-Dec 24
Mountain Burger, Radiant Day Spa & Worthy Brewing
• 1 free basic shake from Mountain Burger ($7 value) and be entered to win $50 gift card and a beanie.
• Be entered to win a $150 gift card for any spa service from Radiant Day Spa
• Be entered to win 1 or 2 $50 gift cards at Worthy Brewing
WEEK 8 – Dec 25-Dec 31
Sisters Coffee, LIOE, Old Mill District & Tower Theatre
• 1 free drink from Sisters Coffee
• Be entered to win a free event bundle from LIOE
• Be entered to win a gift bundle from Old Mill District
• Be entered to win a $100 gift card to Tower Theatre
CATEGORY SPONSOR





















EDUCATION, FAMILY & CHILDREN
MEET OUR LOCAL NON PROFITS
at: project
Bend Parks & Recreation Foundation
BEAM
Bend Endurance Academy
Big Brother Big Sisters of Central Oregon
Boys & Girls Clubs of Bend
Better Together Central Oregon
CASA of Central Oregon
Cascade Youth & Family Center
Central Oregon Disability Support Network
City Club of Central Oregon COCC Foundation
Deschutes Children’s Foundation
Desert Sky Montessori
Every Child Central Oregon
Family Resource Center
Heart of Oregon Corps
Healing Reins Equine Assisted Services
J Bar J Boys Ranch KIDS Center
Kindred Connections
Mountainstar Family Relief Nursery
New Each Morning
Saving Grace Sisters GRO SMART reading
The Jasper Fox Project Treehouse Therapies Associates
As the local responders for the National Human Tra cking Hotline, the at: project (Anti-Tra cking Project) works directly with victims and survivors of human tra cking in Central Oregon. We support adult and minor survivors of sex and labor tra cking with crisis intervention and long term case management to promote healing and empowerment.
The at:project also coordinates the Anti-Tra cking Alliance of Central Oregon (ATACO) which is a multidisciplinary collaboration of agencies working together to coordinate and leverage local resources to provide a comprehensive approach to human tra cking and exploitation that brings trained, skilled, trauma-responsive service to identify and recovers victims of human tra cking; proactively investigate, identify, apprehend and prosecute those engaged in human tra cking; and provide trauma-informed, survivor-centered services to those impacted by human tra cking and exploitation.
We are J Bar J Youth Services


ABOUT US
Say YES!
work in Bend and finding the money to pay for essential programs like afterschool care and swim lessons or the chance for their children to play on a team. Your donation to Bend Park and Recreation Foundation can help by providing the resources needed to take part in Bend Park and Recreation District activities that can improve health, develop confidence and independence, and enrich lives.
To learn more about the recreation scholarship program and how you can help, visit bendparksandrec org/give
This profile is sponsored by:




B
ABOUT US
BEAM’s mission is to create an inclusive, supportive, and engaging environment where children with disabilities, trauma histories, and complex behavioral needs can thrive We provide evidence-based social-emotional learning, academic support, and restorative practices that build confidence, connection, and resilience empowering every child to succeed in school, in relationships, and in life. Our specialized after-school program provides critical support and addresses a gap in services for children who often face exclusion from traditional after-school care and disproportionately experience shortened school days, suspensions, and social isolation
At BEAM, we help children rediscover their light. As one student put it: "Before BEAM I almost always felt like a dark star in a bright sky, and now I feel like a bright star lighting up a dark sky." We believe everyone belongs. No exceptions
EDUCATION, FAMILY & CHILDREN


ABOUT US
Since 2009, Bend Endurance Academy has helped Central Oregon youth grow through Rock Climbing, Mountain Biking, and Nordic Skiing. We believe outdoor experiences build confidence, resilience, and lifelong healthy habits.
Our mission is to champion active living and a passion for sport through inclusion, personal growth, and community engagement - cultivating compassionate, capable young leaders.
Serving more than 1,000 families each year, we’re committed to keeping programs welcoming, inclusive, and accessible. With community support, we lower financial barriers and open doors for more youth to experience the life-changing benefits of sport and recreation.
Why Your Support Matters
• Increase Access: Expand tuition assistance and scholarships so all kids can participate.
• Keep Programs A ordable: Maintain high-quality coaching and outdoor opportunities at accessible costs.
• Support Youth Development: Build confidence, perseverance, and belonging through sport.
• Strengthen Community: Connect families through shared experiences and local events.
Your contribution helps create opportunities for young people to stay active, build confidence, and discover their potential through meaningful outdoor adventures.
Donate today and empower the next generation. Learn more at www.bendenduranceacademy.org





This profile is sponsored by
Support the Bend Endurance Academy: Empower Youth Through Outdoor Adventure
B EN D EN D U R

BIG
ABOUT US
EDUCATION,
Mentorship remains one of the most powerful tools we have to close the gap between people and possibility. The power of mentorship lies in the moments that spark curiosity, aspiration, and inspire potential. Maybe it was the coach who encouraged you to keep going. The guidance counselor who insisted your dreams were within reach. Even the littlest moments can grow into big ones – with a little encouragement, a little hope, and a little inspiration.
You don’t need to have a specific title, a degree, or any special qualifications other than being compassionate, patient, and accepting. You don’t have to be perfect, you just have to be present. It takes a little time, a little encouragement and a laugh or two, so that every child has what—and who—they need to achieve a BIG and brighter future.
90% of Bigs with Big Brothers Big Sisters are proud of their time mentoring. 85% of alumni believe their involvement changed their life for the better. Mentors, called Bigs, say they benefitted from their mentorship relationship just as much, if not more, than their Littles.
You have a big opportunity in front of you—to not only impact a child’s life today, but to transform their potential for tomorrow.
Become a Mentor. Go Big Today.
We’re always looking for people eager to positively impact a child and improve their community at the same time. Big Brothers are especially in high demand. Nationwide, more than 70% of children waiting for a Big are boys, but only 3 out of every 10 inquiries to volunteer come from men. Research shows that having the positive influence of a mentor makes a real di erence in a kid’s life.
For a few hours, a couple times a month, you can give a Little the invaluable gift of your friendship. By simply changing their perspective of what the world can o er, you can literally start changing their life. Play a board game. Make fun crafts. Hit the playground together. Just as your options are unlimited, so is your Little’s potential. It takes LITTLE to be BIG.
We are J Bar J Youth Services
ABOUT US



Change is part of every child’s journey. Your support helps us meet that change with consistency, care, and opportunity. At BGCB, we provide a safe and nurturing environment where youth can build meaningful connections with trusted mentors and engage in life-enhancing experiences. Your support helps them stay on the path to success, encouraging growth, learning, and development in a supportive setting.
BGCB by the numbers:
350 Members Served Each Year
140 Kids Attend Daily During the School Year
60% of Families Receive Financial Aid in the Form of Scholarships
43% of Members Qualify for Free or Reduced School Lunch
Last year, thanks to your generosity, we provided over $400,432 in financial aid to families in need. However, the demand for financial support continues to grow. This fall you have the opportunity to make a profound impact on the lives of Central Oregon’s students.
$25 helps provide healthy snacks for Club kids each week.
$100 supports hands-on STEM learning and creative projects for Club members for three months.
$350 covers one month of full-time afterschool Club tuition.
Your Support Makes Every Season Count Give today to ensure youth in our community are supported from classroom to summer break and back again.
DOUBLE Your Impact! When you become a monthly donor, Hayden Homes will match your gifts through the end of the year—doubling your impact for local youth.





B ETT E R T O G E THE R C E NT RA L OREGO N
ABOUT US
EDUCATION, FAMILY & CHILDREN
Better Together is building a future where every child has the chance to thrive.
In partnership with 400+ cross-sector partners, we support 67,000+ children and youth across
We bring people and organizations together to tackle challenges no one can solve alone.
Whether you give $5 or $500, your support fuels work that:
• Brings schools, families, and partners to the same table to spark action.
• • Breaks down barriers to opportunity.
• Strengthens homegrown solutions led by and for our community.
Your donation to Better Together is an investment in hope, connection, and a more resilient Central Oregon. Thank you!
A S A OF CENT R AL O R E G O N
ABOUT US
Who We Are


CASA of Central Oregon stands up for children who have experienced abuse or neglect. We make sure they are seen, heard, and not forgotten in the court system.
What We Do
We recruit, train, and support volunteers who advocate for the best interests of children in foster care. CASA volunteers work closely with judges, attorneys, and community partners to help every child find safety, stability, and a permanent home.
Our Impact
Last year, CASA volunteers served 78% of children in foster care across Central Oregon.
Our goal is to reach 100% of children in foster care. With your support, we can reach every child who needs a voice.
Why It Matters
Children with a CASA fare better in school, receive vital services more quickly, are half as likely to re-enter foster care, and report higher levels of hope.
Just $50 helps train a new CASA volunteer to advocate for a child in crisis. Your gift today helps recruit and train CASA volunteers who stand beside children in foster care ensuring they are heard, supported, and never alone.
C A
S C ADE YO U TH A N D FAM I LY CENTE R
ABOUT US








At Cascade Youth & Family Center (CYFC), we provide a holistic continuum of care to end youth homelessness:
Emergency Shelter: CYFC provides short term shelter for teens who are homeless, on the streets, or have run away.
Crisis Intervention: We o er crisis intervention services, including family mediation.
Street Outreach: Our outreach team o ers supplies and assistance to youth experiencing homelessness. They also sta drop-in hours where youth can access showers, laundry facilities, and nutritious meals.
Transitional Living: This program o ers longer-term support and focuses on personal accountability at the LOFT in Bend and Canal House in Redmond. Here, youth receive the tools they need to complete their education and develop essential life skills.
Independent Living: Our case managers work with current and former foster children, providing guidance and mentorship to navigate the challenges of independent living successfully.
Supportive Housing: This program supports young adults ages 16-24 as they work toward independence, o ering stable housing and case management in a setting that promotes self-su ciency. Unlike our Transitional Living program with 24-hour support, Supportive Housing provides a step toward independent living for those who need less intensive daily oversight.
Every step of our continuum of care helps young people gain the tools, confidence, and resilience to build healthy, self-su cient lives. CYFC is the only shelter and program of its kind within 150 miles—helping youth not just survive homelessness, but overcome it.
Get Involved: Whether you’re interested in donating or simply spreading the word, your support helps our mission.
November is National Runaway Prevention Month (NRPM), a public awareness campaign designed to shine a light on youth who have run away and experienced homelessness that too often remain invisible.
Once a young person faces the instability associated with homelessness, whether they are couch surfing, staying in shelters, or sleeping on the streets, the consequences can be far-reaching. Some youth, including young people who identify as Black and/or African American, LGBTQIA2S+, non-White, and/or unmarried and parenting, experience homelessness at significantly higher rates compared to their peers. Our goal is to work with homeless youth to prevent them from becoming homeless adults.
We are J Bar J Youth Services
Together Central Oregon
(541) 745-4355
bettertogether@hdesd.org
bettertogethercentraloregon.org



C

CENTRAL OREGON DISABILITY SUPPORT NETWORK
ABOUT US
Central Oregon Disability Support Network (CODSN) helps children with disabilities and their families navigate life from the very beginning through young adulthood. Many families feel lost trying to understand medical, school, and service systems — especially in rural areas where help can be hard to find.
CODSN provides guidance, family events, and practical trainings that make it easier to find answers, connect with others, and build confidence. Our team is made up of parents and people who have lived these experiences, so families know they’re not alone.
Serving eight rural Oregon counties, we work every day to make sure families raising children with disabilities have the tools, support, and community they need to thrive.

Our Mission
To create a more informed and engaged community by creating learning opportunities and fostering meaningful dialogue that inspire responsible civic involvement.
About Us
At City Club of Central Oregon, we believe that communities thrive when everyone has the chance to learn, engage, and make their voices heard. We bring Central Oregonians together for open, respectful discussions on the issues that matter most to our region—whether it’s local governance, environmental challenges, or community well-being. Through public forums and events, we connect neighbors and leaders, transforming complex issues into informed discussions that empower citizens and shape the future of our community.
Our Goal
To build a more informed, connected, and civil community where individuals can explore ideas, share perspectives, and make better decisions for Central Oregon.
CO CC F OUN DAT IO N
WHO ARE WE

Since 1955, COCC Foundation scholarships have enabled students to learn new skills, earn technical certificates, complete two-year associate degrees and be prepared to pursue the remainder of their undergraduate studies at a college or university
WHAT WE DO
Our scholarships provide financial support, but for many students being a scholarship recipient means something more. It means someone believes in them enough to provide them with the financial resources needed to attend COCC. It means someone else believes in their dreams.
DES
ABOUT US



Deschutes Children’s Foundation is a safe haven for children and a home for the nonprofits that serve them Each year, tens of thousands of vulnerable children and families seek essential resources at our campuses. With 23 nonprofit partners across four DCF locations in Redmond, Bend, and La Pine, we work together to ensure families have what they need to not just survive, but thrive Families can access vital services such as infant essentials, therapeutic care, early childhood education, nutrition assistance, and more
The demand for our services in the community is ever-growing, and you can help! We envision a community where all children and families have the resources they need to thrive, and you can play a key role in making that vision a reality Contributions to Deschutes Children’s Foundation support our mission of providing the space and support necessary for nonprofits to succeed in helping children and families



CITY CLUB OF CENTRAL OREGON

DESERT SKY MONTESSORI
ABOUT US
EDUCATION, FAMILY & CHILDREN
Desert Sky Montessori is Central Oregon’s only tuition-free public Montessori Elementary School. As a public charter and nonprofit, we serve a diverse community and are committed to bringing the highest quality, Montessori-based education to our students.
Children at Desert Sky benefit from individualized and self-paced lesson plans, and a smaller student-to-teacher ratio.
Our teachers and sta are committed to the development of the whole child through a curriculum rooted in Montessori philosophy and principles.
Our mission is to provide all children with an environment for joyful exploration that fosters self-discovery and a life-long love of learning.
Your contribution will help us extend our reach and empower more students to develop into successful people that will impact our community here in Central Oregon and beyond.
EVERY CHILD CENTRAL OREGON
ABOUT US





Every Child Central Oregon exists to support children and families impacted by foster care through tangible goods, volunteer engagement, and community mobilization. Our mission is to create a community where every child experiencing foster care feels seen, valued, and supported. We work across Deschutes, Je erson, and Crook Counties, including the Confederated Tribes of Warm Springs, connecting those who want to help with the real-time needs of children and families navigating the child welfare system.
Our support extends to families providing foster care, youth who have recently aged out of care, and biological families who have reunified with their children. Through our My NeighbOR tangible goods support program, we experienced a 325% year-over-year growth, serving more families than ever from our centralized Redmond warehouse by fulfilling hundreds of requests for essential items like clothing, diapers, hygiene supplies, and more. In addition to this critical support, our organization recruits new resource foster families, engages community members through volunteer-driven programs, and o ers intentional resource foster family retention e orts—all designed to ensure children in care are surrounded by stability, dignity, and a deeply connected community. By empowering our community to show up with purpose and compassion, we work to improve outcomes and create a stronger, more connected foster care system in Central Oregon.
ABOUT US



At Family Resource Center of Central Oregon, we believe every family deserves access to tools and support needed to thrive. Parenting is one of life’s most important and sometimes most overwhelming jobs. That is why we provide education, coaching, and resources that empower parents to raise healthy, confident, and resilient children.
Your donation makes a direct impact as every dollar you give invests in the future of our community.
Parenting support is powerful prevention. When parents feel supported, children feel secure, and families grow stronger together.
This season, we are leaning into our caring community to make a lasting di erence. Your gift will last for generations.
Join us in building stronger families and a stronger Central Oregon.
HE A R T O F O
ABOUT US
E G O N CORPS

1 in 8 Oregon youth are disconnected from school and work—but not at Heart of Oregon Corps.
For 25 years, we’ve trained rural and underserved youth in careers that solve Central Oregon’s biggest challenges: construction, childcare, wildfire risk reduction, and public lands conservation. Since 2000, more than 5,000 young people have built skills and confidence through our programs. Now, we’ve outgrown our aging, borrowed facilities. To meet the demand and serve 225 youth each year, we’re building a new $7.3M, 3.4-acre campus in Redmond—a place where youth can learn, earn certifications, and launch careers that strengthen Central Oregon communities for generations to come. Youth on the workforce track need a campus, too—help us build it!





EDUCATION,
At Healing Reins, we meet people where they are, in wide open spaces full of movement, connection, and possibility. Every day, children and adults of all abilities experience life-changing moments through equine-assisted services, nature-based pediatric therapies, and mental health programming. But as the need for services grows, so does the number of
and we've seen a sharp increase in the need for this funding that we can not keep up with. By giving through Central Oregon Gives, you’re not just donating; you’re opening the barn doors, the pasture gates, and the path toward healing for every person who needs it, regardless of their ability to pay. You're ensuring the 275 people per week that access our services continue to access, and that we never have to turn anyone away
Your donations make a significant impact:
$25 – Helps us reach rural Central Oregon families who might not otherwise know healing is possible. Your gift fuels outreach and ensures everyone has a path to our ranch
$50 – Covers a participant’s initial welcome and orientation experience. This is the first time they meet their therapy team, and begin their healing journey
$100 – Underwrites the cost of one therapy session, making equine-assisted or nature-based therapies accessible to families who need financial assistance
$200 – Supports training and resources for our 80+ weekly volunteers, ensuring every participant has a safe, supported, and compassionate experience
$500 – Provides essential health care and wellness support for our Healing Herd — the partners who make breakthroughs possible
$700 - Fully funds a scholarship for one participant for an entire session, ensuring that financial hardship is never a barrier to receiving care.
$1,000 – Invests in expanding program capacity supporting new therapists, animals, and equipment needed to meet the growing demand for services.
$3,000 – Sponsors a horse for a full year — covering its care, feed, training, and wellness, so it can continue changing lives
ABOUT US


J Bar J Boys Ranch is a residential treatment program for teen boys involved in the juvenile justice system, providing an opportunity to restructure thinking, succeed academically, and grow in responsibility.
The newest initiative on campus is a vocational program. By providing vocational training in addition to a strong academic curriculum, the opportunity for gainful employment increases. Meaningful employment reduces the likelihood of engaging in criminal behavior and the training helps to build a workforce. Help boys who have made poor choices build a brighter future and become contributing members of the community.
We are J Bar J Youth Services
ABOUT US

KIDS Center is the local nonprofit leading our region’s child abuse. As the Children’s Advocacy Center for Central Oregon, we provide no-cost child abuse evaluations, therapy and family support to hundreds of children and families each year. Since opening our doors in 1994, KIDS Center has helped more than 17,000 children and families find hope and healing
safer place for kids.



J BAR J BOYS RANCH

KI N D RED CONN E C T IO N S
ABOUT US
EDUCATION, FAMILY & CHILDREN
Helping Families in crisis who lack a safety net: Mobilizing and equipping mentoring families and area church communities to provide support while parents work to secure stability for their families.
We provide families in crisis with mentoring relationships for parents and temporary housing for children. We connect families with needed support during a time of challenge, including possible job loss, serious illness, homelessness, or other issues that complicate parenting. By surrounding families with compassion and practical help during di cult times, we keep children safe and families together.
We are J Bar J Youth Services

At MountainStar Family Relief Nursery, we care for children ages 0–5 — the most critical years for brain development, and the time when our community sees the highest rates of child abuse and neglect. By surrounding families with care and connection early on, we help prevent crises before they happen
In our therapeutic classrooms, little ones learn to understand their emotions, build healthy relationships, and gain confidence that lasts a lifetime. During home visits, parents receive personalized support and guidance to strengthen their parenting skills and keep their children safe.
Your support gives children and parents the chance to grow in safety and stability—creating a stronger Central Oregon where every family has the opportunity to thrive

Serving 1,315 community members in La Pine, Bend, Redmond, Madras, Warm Springs, and Prineville


P
r t Specialists, life-skills m e nt o ring, a nd p r acti c al r es o u r ces that resto r e dignity, r e un ite families , and b u ild acco un tability
Ou r S tabl e Hou si n g A ssista n ce P r o j e ct u rge n tly n eeds yo ur h elp t o p



Saving Grace o ers safety, hope, and healing to survivors of intimate partner violence and sexual assault — and engages Central Oregon to build lives free from violence.
HOW DONATIONS CAN HELP US
$50 – Provides gas for a survivor fleeing intimate partner violence
$100 – Provides a security camera for safety in a survivor’s home
$250 – Provides a safe hotel stay for a survivor and their children
$500 – Provides 3 weeks of meals for survivors at shelter
$1,000 – Provides rental assistance to survivors
Donations made through Central Oregon Gives will be matched, up to $95,000, thanks to an anonymous donor and the Eccles Coit Family Foundation.


M

S I STE R S G R O
ABOUT US
Sisters Graduate Resource Organization (Sisters GRO) helps Sisters High School graduates embark with more than a diploma they begin their post-secondary journey with a scholarship that reflects their community’s belief in them Sisters GRO raises, receives, and distributes scholarship funds; administers the application process; and supports students as they plan their educational futures
Since 2009, thanks to the generosity of local families, businesses, and organizations, Sisters GRO has distributed over $3.1 million to help SHS graduates pursue college, trade, and technical programs. These scholarships reduce financial barriers and inspire students to give back by becoming more. We are deeply grateful to our donors past and present—who continue to grow funds for GROwing futures. Together, we’re building a community where every student has the opportunity to thrive beyond high school.


ABOUT US
SMART Reading is a children’s literacy nonprofit that serves kids in Oregon’s highest-need schools with two ingredients critical for literacy and learning success: shared reading time and access to books. We mobilize volunteers to read with PreK through third-grade children, building confidence, literacy skills, and a love of reading. Kids in our program get to choose and keep 14 books a year to build their own personal libraries!
Simply put, life is harder when children can’t read proficiently. Reading is a critical gateway skill that paves the pathway for successful futures. Without it, kids are less likely to graduate from high school or find gainful employment as adults, leading to a host of additional hardships. Building a strong foundation of literacy can change a child’s life trajectory, and can help prevent and alleviate issues of poverty, homelessness, hunger, and injustice.
THE JA SPE R F OX P R OJ E C T
ABOUT US

The mission of The Jasper Fox Project is to comfort families who have experienced stillbirth, miscarriage, exact birth weight of a child who passed away These foxes are personalized and unique gifts meant to foxes to families in 40 states and 3 countries internationally
We have begun networking with local churches and resource centers to be a readily available service when a community member experiences a loss. In a situation where
sweet gift to be sent to those who are grieving. Our goal is that no family would have empty arms after a loss
All donations go directly to the making of foxes, materials, and covering all shipping costs. Thank you so much for your support!
TREEHOUSE THERAPIES
ABOUT US




At Treehouse Therapies, we bring to life our mission, to unlock the limitless potential of children, families and community by providing exceptional care regardless of financial limitations. With locations in Bend, Redmond, Sisters, and Warm Springs, we make sure that every child with special needs, from birth through adolescence, can access essential physical, occupational, and behavioral health therapy, regardless of their family's financial situation.
Our team of physical, occupational and behavioral health therapists help children with a variety of conditions including development delay, cerebral palsy, autism, sensory processing disorders, down syndrome, and behavioral health challenges including ADHD, PTSD, anxiety, depression and more. We help children gain confidence, build new skills, improve functionality, reach their utmost potential, and live their best lives.
Help us ensure that cost is never a barrier to care! Together, we can open doors, remove obstacles, and give every child the chance to thrive.




Treehouse Therapies
This profile is sponsored by:
SMART READING

ARTS & CULTURE
ABOUT US
At BEAT Children’s Theatre, we believe in the power of theatre to inspire and empower youth. Through creativity, confidence, and connection, young people discover who they want to be.
Demand for our programs exceeds capacity—a great challenge! With your support, we can grow: expanding sta , space, and access while keeping costs low for families.
We serve Central Oregon through performances, classes, camps, and outreach, o ering 3–4 main stage productions and 15–20 camps/classes each year—reaching up to 400 young artists. Our Cultural Student Productions bring 2,400 elementary students to live theatre annually, while school residencies, bilingual programs, and free community events extend our impact to several thousand more Central Oregon students.
Please consider supporting BEAT today. Our donors and partners make it possible to ensure that financial barriers never stand between a young person and their potential. BEAT is a 501(c)(3) nonprofit, and all gifts are tax-deductible.
THE OPEN ARTS CENTER
ABOUT US


In January 2026, the Open Arts Center will celebrate its grand opening as Bend’s new creative home: a community-driven space for teens and adults to foster creativity, intergenerational learning, and belonging.
At the heart of our program is our free teen center, a place for them to gather, connect, and explore their creativity through the arts. Your donation helps us keep all of our teen programming free, including self-directed learning, classes and workshops, and one-to-one apprenticeship opportunities with creative professionals. With your help, we will nurture curiosity, empower voices, and provide resources for everyone in our community to discover and develop their creative identity.
To learn more and support our mission, visit theopenartscenter.org and follow us @theopenartscenter.






BEAT CHILDREN’S THEATRE

ABOUT US
Support BendFilm — Where Independent Voices Inspire Our Community
BendFilm believes in the power of independent film to connect people, spark conversation, and inspire change. As a nonprofit, we champion diverse filmmakers and bring bold, thought-provoking stories to audiences across Central Oregon through our year-round programs and our 22nd Annual Bend Film Festival, which now welcomes over 10,000 attendees across theaters, pop-up venues, and community spaces.
Your donation keeps the arts accessible to everyone — from free outdoor movies in local parks to hands-on education initiatives like Basecamp, our immersive filmmaker retreat, and our youth summer filmmaking camps, where scholarships ensure that cost is never a barrier to creativity.
With your support, BendFilm continues to:
• Present more than 130 independent films, and host more than 100 filmmakers from around the world each year.
• Elevate underrepresented voices through our Indigenous Film Program, created in partnership with Warm Springs filmmakers and cultural leaders.
• Operate the Tin Pan Theater 365 days a year, bringing independent, classic, and international films — plus special events — to the heart of downtown Bend.
• Collaborate with local businesses and nonprofits dent film experiences to every corner of our region.
Every contribution — large or small — fuels creativity, builds empathy, and strengthens the arts in our community. Give today and help keep independent film alive and thriving in Central Oregon.
L AY I T OUT F O UN DATI O N
ABOUT US








Supporting Independent Journalism in Central Oregon.
For 28 years, The Source has been a locally owned, independent voice for Central Oregon. As an unwavering watchdog, The Source remains beholden to no one and carries no political agenda—prioritizing transparency, integrity, and truth to deliver real journalism in a completely free publication.
Central Oregon Gives is a project of the Lay It Out Foundation, amplifying our impact by directing essential resources to where they’re needed most. Through this work, we strengthen community bonds, foster a collective spirit of responsibility, and help make Central Oregon a stronger, more inclusive, and resilient region.
Your contributions to the Lay It Out Foundation sustain independent, high-quality journalism that keeps readers informed about the critical news, culture, and events shaping our region. Support for the Foundation empowers The Source to deepen its role as a vital community resource—delivering impactful stories that matter.
Thanks to generous community support, the Lay It Out Foundation funds a full-time investigative reporter. Peter Madsen brings essential stories that serve the public good. And now, thanks to growing community support through the Source Member Program, we’re close to expanding this team even further with another full-time journalist, allowing us to deepen coverage and continue serving Central Oregon with integrity and insight.
We invite you to join us in our mission to keep Central Oregon informed, engaged, and empowered. Every contribution—no matter the size—goes directly toward sustaining independent journalism and the shared mission of keeping our community connected.
Thank you for standing with us! Your support means everything.
The Lay It Out Foundation abstains from the category prize competition.



The Source is Powered by

ABOUT US
At OUT Central Oregon, we work to ensure the 2SLGBTQIA+ community and our allies not only feel included but thrive. By fostering dynamic partnerships with businesses, government entities, and other organizations, we create an exciting, supportive environment that encourages community involvement and celebrates diversity. Together, we build a vibrant, inclusive culture that empowers everyone to flourish in Central Oregon.
Powered by a passionate, all-volunteer team, OUT Central Oregon serves as the essential
full spectrum of joyful events—from intimate pop-ups to our beloved annual Winter PrideFest. Your donation directly fuels our work to transform Central Oregon into a vibrant region where every single person is celebrated, supported, and empowered to thrive.
Highlights of some recent activities are included below:
• Annual production of Winter PrideFest, the only multi-day and multi-event celebration of inclusivity in the outdoors in the PNW, with approximately 2,500 attendees in 2025
• Produced a panel discussion primarily related to Trans and Non-Binary health topics, Queer civil rights, and 2SLGBTQIA+ housing during June Pride
• Hosting 2SLGBTQIA+ Social Mixers through the year
• Distributed over 79,000 YOU ARE WELCOME HERE progress pride flag stickers to individuals, businesses, school districts, and cities/towns
• Promote other 2SLGBTQIA+ focused organizations and their initiatives by providing paid promotion, social media outreach social media marketing, and inclusion of their events on our Community Events Calendar
• Support of other 2SLGBTQIA+-focused and marginalized community groups on the High Desert, both financial and in-kind
Your Donation will provide:
Provide critical funding needed for OUT Central Oregon to continue to serve our 2SLGBTQIA+ community currently facing significant challenges:
• Enhance Winter PrideFest 2026 with new community events
• Continue to expand and enhance local and regional meetup events to help reduce isolation and connect people
• Continue to expand and build the resource and support networks for 2SLGBTQIA+ community.
• Continue our YOU ARE WELCOME HERE sticker program to provide Central Oregonians an opportunity to increase visible support for the 2SLGBTQIA+ community
SCALEHOUSE COLLABORATIVE FOR THE ARTS
ABOUT US
Scalehouse Collaborative for the Arts is Central Oregon’s home for contemporary art, creativity, and connection.



We bring people together through rotating exhibitions, artist talks, and hands-on programs that spark curiosity, reflection, and conversation. We also support students—from kindergarten through college—by welcoming school groups to the gallery, connecting them with practicing artists, and o ering experiences that build creative skills, confidence, and a love of art.
By supporting Scalehouse, you help keep our community vibrant, our local artists thriving, and contemporary art accessible to everyone in Central Oregon.
Your contribution helps make art a part of daily life, inspiring connection, imagination, and a sense of belonging for all who visit.




scalehouse org






VRCCO 24/7 Emergency & Specialty Hospital 62889 NE Oxford Ct. Bend, OR 97701
Ph: 541-209-6960
Urgent Care Center at VRCCO 1820 NW Monterey Pines Dr. Bend, OR 97703
Ph: 541-204-1261
www.vrcvet.com









ANIMAL WELFARE
MEET OUR LOCAL NON PROFITS
Brightside Animal Center
Companian Animal Medical Project
Dogpac
Embers Wildflower Animal Santuary & Bunny Rescue
Furry Freight
Happy Trails Horse Rescue
Harmony Farm Sanctuary
BRIG H T S I DE AN IMAL CENTE R
ABOUT US
Humane Society of Central Oregon
Lark Ranch Rescue and Rehabilitation
PET Evacuation Team
Pets Forward
Street Dog Hero
Riley May Rescue Ranch
Think Wild
Help BrightSide Animal Center Support Our Growing Community of Animals in Need!
At BrightSide Animal Center, we are dedicated to reducing animal homelessness and preventing unnecessary euthanasia. Our shelter plays a vital role in Central Oregon, providing essential services like sheltering, placement, and prevention programs.
As our community grows, we face significant challenges, including a troubling rise in homeless animals entering our shelter and an increase in families surrendering pets due to financial hardships. This has led to more animals needing our help more than ever before As a 501c3 nonprofit, BrightSide relies on grants, adoption revenues, donations, and income from our beverage recycling program and thrift store
Before animals leave our care, they receive comprehensive medical attention, including vaccinations, microchipping, and spaying or neutering, ensuring they are fully prepared for their new homes.
To continue our life-saving mission, we seek financial assistance to provide necessary care for these animals and support our community Every animal deserves a chance at a secure future and at the core of our mission is a commitment to giving animals a second chance at a fulfilling life. BrightSide serves as their voice, advocating for those who cannot speak for themselves.
Your donation, at any level, helps us save lives:
$20 can vaccinate a shelter cat.
$50 covers microchipping five animals.
$250 covers a dog’s spay or neuter surgery
$500 supports two dog adoptions.
$750 buys a month’s worth of kitty litter for the shelter
$1,000 supports one month of dog and cat food for the shelter


Thank you for your support and helping us create brighter futures for pets and people!


ANIMAL WELFARE
COMPANION ANIMAL MEDICAL PROJECT (CAMP)
ABOUT US
Companion Animal Medical Project (CAMP) has been serving Central Oregon since 2020, providing no-cost veterinary care and pet-retention services for individuals experiencing homelessness
figuratively and literally
Through our mobile clinics, outreach, and partnerships, we aim to strengthen both ends of the leash. Our services include wellness care, vaccinations, spay/neuter, urgent medical assistance, pet deposits, fostering, rehoming, and now, shelter and housing navigation - helping people move from homelessness to shelter without leaving their pets behind
At CAMP, we believe no one should have to choose between their own needs and those of their companion animals
ABOUT US


We are a Bend-based volunteer group that has been instrumental in humans since 2008.
We believe that good dogs and their responsible humans should have designated outdoor spaces where they can roam free as nature intend ed.
We also believe that we have a responsibility to be good stewards of spaces.
Your donations fund everything we do including:
• Pet-waste removal services at Good Dog! (Rimrock Trailhead), Phil’s Trailhead and the dog-friendly Wanoga Nordic ski and snowshoe park.
• Grooming the Nordic ski trails at Wanoga Sno-Park.
• Advocating for more dog-friendly,
We are grateful for your support!





ABOUT US
Ember’s Wildflower Animal Sanctuary and Bunny Rescue is a registered nonprofit 501(c)(3) established in 2019. We are the only bunny-specific rescue serving Central Oregon and surrounding regions
Your gift allows bunnies to arrive at our rescue to experience, sometimes for the first time, a feeling of safety, a caring voice, healing and pain relief, a rabbit-appropriate diet, grooming freedom to stretch and run and joy. Bunnies at our rescue will be given the opportunity to find a carefully vetted forever home. If they have health or behavioral needs that preclude them from adoption, Ember’s will provide lifelong sanctuary Bunnies are the third most abandoned pet after cats and dogs, and we work to reduce the cycle of surrendering unwanted domestic bunnies by providing educational resources, carefully reviewing potential adopters, and ensuring good matches between humans and companion animals
$500 – Provides emergency veterinary care for a bunny in crisis
$250 – Supplies fresh hay for our sanctuary residents for 2 weeks
$150 – Covers the cost of a spay or neuter surgery
$50 – Buys toys, enrichment, and comfort items for one bunny
$35 – Provides an annual RHDV2 vaccination
$15 – Covers the cost of a microchip
When you donate, your gift this season will be doubled thanks to a generous donor providing a $1,500 matching fund!


D O G P A C

ABOUT US
Our mission is to save shelter pets one road trip at a time.
We help at-risk animals in severely overpopulated areas escape the risk of euthanasia by giving them a safe ride to our rescue partners throughout the Pacific Northwest. Our volunteers drive as far as Oklahoma, Texas, and Central California to pick up our furry passengers and deliver them to safety
In addition, our Spay it Forward Program combats the root cause of this crisis by directly supporting low cost spay/ neuter surgery in these overpopulated areas where owners in low-income families can have their pet fixed at low cost or free. This program prevents thousands of puppies from entering already overcapacity shelters
Your generosity directly saves lives and any amount is greatly appreciated.
HAPPY TRAILS HORSE RESCUE
ABOUT US
Happy Trails Horse Rescue is dedicated to the protection of horses and their quality of life. While we strive to rescue those horses in need, we also provide community outreach, education and resource - such as our SURRENDER PREVENTION PROGRAM (food, medical/farrier assistance or temporary shelter) in an effort to alleviate an owner’s difficult choices of relinquishment or euthanasia. We believe that every equine deserves compassionate care and unconditional love, regardless of age, health, or behavior.
$25 = One Microchip for one horse
$50 = One Farrier trim for one horse
$100 = Hay for one horse for one month
$250 = Basic needs for one rescue horse for one month
$750 = Pain medicine for one horse for one year
$1000 = Cushings medicine for one horse for one year
HA R M O NY F ARM SA NCT UAR Y
ABOUT US

Harmony Farm Sanctuary (HFS) is a 501(c)(3) nonprofit, volunteer-run and proudly accredited by the Global Federation of Animal Sanctuaries (GFAS). For more than a decade, HFS has been a safe haven for over 150 rescued farm animals and has rescued, rehabilitated, and rehomed more than 1,200 animals in need. From pigs and cows to llamas, goats, sheep and chickens, every resident carries a story of resilience—of survival, of second chances, of hope.
When our residents arrive at Harmony, they’re not just safe. They’re home. Forever. A place where they root, roam, stretch out in the sun, and finally exhale.
Beyond rescue, we welcome hundreds of community members each year through our compassionate curriculum programs—including at-risk youth connection, and empathy through time spent with our residents.
We’re striving to raise $75,000 to continue our life-saving work for animals and people in our community. Your gift will directly support critical safety upgrades: building a much-needed shelter for our sheep, making vital farm improvements to protect both our residents and volunteers, and purchasing a large trailer for emergency evacuations during wildfires and other disasters-ensuring no animal is ever left behind.
Every contribution, large or small, grateful for the incredible support of our community.




























HUMANE SOCIETY OF CENTRAL OREGON
ABOUT US
The Humane Society of Central Oregon (HSCO) has been a lifeline for pets and people since 1961. As a Socially Conscious Shelter, HSCO is dedicated to achieving the best possible outcome for every animal, serving seven counties across a 100-mile radius.
Your support makes hope possible:
• Safe shelter and second chances for thousands of pets each year
• Accessible veterinary care for animals in underserved communities
• Foster homes and lifesaving support for fragile puppies, kittens, and senior pets
• Swift response to cases of neglect and abuse, providing safety, medical care, and a path to recovery
• Programs that keep families together, helping pets stay with the people who love them even during crisis
A gift to HSCO doesn’t just save lives - it transforms them. Together, we can create a safer, healthier, and more humane Central Oregon for animals and their families.

ABOUT US

Lark Ranch Rescue and Rehabilitation is committed to helping animals have better lives through a number of programs. We run an animal sanctuary with 71 animals on site; each with their own story of hardship and redemption. We also provide free medical care and surgeries for other rescue groups and community cats. We have performed over 800 spay and neuter procedures on feral cats over 6 counties through our Trap-Neuter-Return program. We have also provided over 300 other surgeries to other non-profit organizations.
LarkRRR has partners over 4 counties who we work with to provide medical care, wellness visits and needed surgeries in multiple species. We work with animal shelters, rescues and groups large and small to make Central Oregon a better place for both animals and people. We ask for your support so we can continue to contribute to our community in this positive way.
P E T E VAC UAT I ON T E A M
ABOUT US
SERVING ANIMALS AND PEOPLE IN CRISIS


Emergency animal evacuations and sheltering during disasters are critical to our community and save lives. PET works in partnership with the Red Cross, law enforcement and local emergency services during Central Oregon disasters, providing care and a safe haven for animals who have been evacuated. We have assisted in disasters for over 20 years, including 21 local wildfire evacuations. PET also assists individuals with animal/pet-related emergencies, and law enforcement in animal seizure cases. Our volunteer-based organization serves all of Deschutes
locations simultaneously, and lasting longer To serve people and pets in crisis PET is seeking donations to help us stay AT-THE-READY with our trucks, rescue equipment trailers and supplies.



L A R K R ANCH RE SCU E A N D R EHABIL I TATI O N

PETS FORWARD
ABOUT US
When the Veterinary Referral Center of Central Oregon opened their doors they quickly recognized that not all pet-parents could
Since then, healthcare prices have continued to rise and economic euthanasia has become more prevalent throughout the veterinary industry. In response, VRCCO partnered with the Veterinary Care Foundation to establish a philanthropic fund dedicated to bridging this gap.
VO LU NTE E R S I N M E D I C I N E
VO LU NTE E R S I N ME D I C I N E
The VRCCO Care fund was created to help financially constrained, neglected, and abused animals access the critical veterinary care necessary to thrive. What started as emergency financial assistance for pets in crisis, quickly grew into a lifeline for families facing heartbreaking choices.
ABOUT US
Right now in Central Oregon, thousands of people without health insurance choose between healthcare and food, childcare, or housing. Without access to medical care, untreated conditions could lead to severe or life threatening illness, visits to the emergency room and overwhelming medical bills.
Through the generous support of donors and community members, the VRCCO Care Fund raised nearly $200,000 in two years, helping countless pets receive the advanced treatments and procedures that allow them a second chance at a long and healthy life. Additionally, more than 300 pets have benefited from rehabilitation therapy to enhance their recoveries, these resources made possible by funding.
What we do
Right now in Central Oregon, thousands of people without health insurance choose between healthcare and food, childcare, or housing. Without medical care, untreated conditions could or life threatening illness, visits to the eme and overwhelming medical bills.
Volunteers in Medicine is our successful, to this terrible dilemma.
What we do


Volunteers in Medicine is our successful, local solution to this terrible dilemma.
Our patients are low-income, working covered by the Oregon Health Plan and
However as the Care Fund grew, so did its vision. The challenges facing pets and their families extend beyond emergency care, they also include access to the advanced treatments, innovations in medicine, and the resources veterinarians need to provide the best possible outcomes.
Our patients are low-income, working adults not covered by the Oregon Health Plan and who cannot
We treat people by partnering with St. pro-bono specialists, and nearly 2,000 doctors, nurses and community members 20 years.
We treat people by partnering with St. Charles, local pro-bono specialists, and nearly 2,000 volunteer doctors, nurses and community members over the last 20 years.
It’s special. We are neighbors taking ca e of neighbors.
Tony’s story
To meet this broader mission, the VRCCO Care fund is currently evolving into PetsForward, a 501(c)(3) nonprofit organization. PetsForward will build on years of community support and philanthropic success to create a larger platform for impact, supporting both pets in need and advancing access to innovative veterinary care options.
It’s special. We are neighbors taking care of neighbors.
Tony’s story
PetsForward is not just a fund, but a growing movement dedicated to compassion, progress, and the advancement of animal care. PetsForward will continue to be the heart of the Care Fund by ensuring pets in financial need get the urgent care they require, but it will also take bold steps to move veterinary medicine forward. With your support, we can ensure that every animal, regardless of financial means, has access to the high-quality medical care they deserve.


Tony is a dishwasher at a local taco shop who began feeling day he fainted at work. When he awoke, his co-worker said him of diabetes. They drove straight to the emergency room, was tested. The co-worker was right: Tony had diabetes.
Tony is a dishwasher at a local taco shop who began feeling dizzy until one day he fainted at work. When he awoke, his co-worker said this reminded him of diabetes. They drove straight to the emergency room, where Tony was tested. The co-worker was right: Tony had diabetes.
Now, with a large medical bill from the emergency room diagnosis, Tony was facing a major question. How would health problem and provide for his family?
Now, with a large medical bill from the emergency room and a new diagnosis, Tony was facing a major question. How would he pay for this health problem and provide for his family?

But the nurse told Tony about VIM. He got a referral to our seen quickly We provided glucose monitoring, education and the medication Tony needs to stay healthy and keep
But the nurse told Tony about VIM. He got a referral to our clinic and was seen quickly We provided glucose monitoring, education about nutrition, and the medication Tony needs to stay healthy and keep working.
Your contribution will help us wag our way forward by supporting the next chapter of the VRCCO Care Fund.
Move PetsForward Today:
“I don’t know what I would have done without VIM,” said Tony “I would probably have gotten sicker, with more complications. It could have spiraled out of control. It’s scary to think about.”
The outcomes
$25 – First Step: Give a little love that leaves a lasting mark.
The outcomes
$50 – Meaningful Advance: Help provide food, comfort, medication or supplies.
In our 20 years, we’ve:
In our 20 years, we’ve:
• Treated 16,000 patients
• Treated 16,000 patients

“I don’t know what I would have done without VIM,” said Tony “I would probably have gotten sicker, with more complications. It could have spiraled out of control. It’s scary to think about ”

$100 – Bold Stride: Support an urgent exam or diagnostics for a pet in need.
• Provided 111,000 patient visits
• Provided 111,000 patient visits
• Racked up 114,000 volunteer hours
• Racked up 114,000 volunteer hours
$250 – Lasting Leap: Give pets a real shot at recovery through testing and treatment.
Change lives with a gift today! ABOUT US
• Provided $150 million+ in medical care and community benefit
• Provided $150 million+ in medical care and community benefit
Change lives with a gift today!
$500 – Taking the Lead: Cover part of a life-saving procedure or specialty care.
$1,000+ the treatment of a pet in need of care.













ABOUT US
Founded in Bend in 2017, Street Dog Hero is a foster-based rescue with a global mission and a local heart. We save dogs in need, whether they are here at home in Central Oregon, in overcrowded U.S. shelters, or on the streets abroad, and give them the second chance they deserve through rescue, adoption, wellness, spay/neuter, and humane education.
By the end of 2025, Street Dog Hero will have rescued and rehomed more than 4,000 animals and provided over 12,000 low- or no-cost surgeries and wellness procedures.
caused by animal overpopulation.
Your support fuels this lifesaving work both here at home and across borders. Together, we are creating stronger, more compassionate communities by helping people care for the animals they love and ensuring that every dog has a chance at a better life.
• $500 rescues a dog from an uncertain fate and covers transport, veterinary care, and placement.
• $150 spays or neuters two pets and provides vaccines and wellness exams for families in need.
• $75 supplies food, training, and enrichment as dogs transition from foster care to forever homes.
• $40 funds an international spay/neuter, begins.
Every contribution creates a ripple of kindness that begins here in Central Oregon and extends around the world - saving lives, inspiring hope, and giving dogs everywhere a chance at a safe, loving home.,






























RYLIEMAY RESCUE RANCH
ABOUT US
ANIMAL WELFARE
RylieMay Rescue Ranch is passionate about providing education towards rescue animals as well as providing a safe, soft place for dogs who would otherwise be euthanized. Our focus is older dogs or dogs with special needs who have found themselves overlooked in over crowded shelters.
RylieMay Rescue Ranch is also fiercely dedicated to saving as many lives as possible and showcasing the full and happy life of adventure that awaits when you rescue an animal. We want to educate about the world of rescue and help as many people as we can find their new furry family members.

ABOUT US
Think Wild is a 501(c)(3) nonprofit wildlife hospital and conservation center based in Bend. Our mission is to inspire the High Desert community to care for and protect native wildlife through education, conservation, rescue, and rehabilitation
At our Wildlife Hospital, we rescue, treat, and release injured and orphaned native animals. Each year, hundreds of patients, from bobcats and bald eagles to hummingbirds, ducklings, and flying squirrels, get a second chance at life thanks to our dedicated
Through our Youth Education programs, we connect students to local ecosystems through field trips, classroom visits, interpretive walks, and summer camps that inspire curiosity and compassion for wildlife
Our Humane Wildlife Services program helps people coexist with native species through safe, nonlethal solutions such as exclusions, deterrents, and habitat installations like nest boxes, bat houses, and raptor perches
And our Beaver Works Oregon program restores streamside habitats with native plants, beaver dam analogs, and citizen science that benefit beavers, fish, and many other species
We are lucky to call Central Oregon home, but the wild animals who share it with us are struggling as the community grows. Wildlife can’t ask for help, and it’s up to us to speak and act for them Please donate to ensure that Think Wild can be there when wildlife need us most.




T H I N K W I L D

CATEGORY SPONSOR
BASIC
NEEDS MEET OUR LOCAL NON PROFITS
Assistance League of Bend
Central Oregon Locavore
Family Kitchen
Furnish Hope
Grandma’s House
Heartwarmers
High Desert Food & Farm Alliance
Sisters Habitat for Humanity Opportunity Foundation of Central Oregon
A S SI STANCE LE AG U E O F BEN D
RootedHomes
Supporting Afghan Families Inc.
The Giving Plate
The Peaceful Presence Project
Thrive Central Oregon
United Way of Central Oregon
For more than 35 years, Assistance League® of Bend has brought comfort, dignity, and hope to local children and adults facing poverty and cancer. Every person who gives or volunteers helps change lives right here in Central Oregon. With no paid sta , every donation stays local—easing burdens and making a real di erence.
Your generosity supports programs such as:
Operation School Bell®, our signature program, provides new clothing, shoes, and books to children in need. Last year, we helped over 2,800 K–12 students in Deschutes County start school with confidence. We also supply emergency clothing for children entering foster care and host a holiday celebration for foster families.
Cinderella’s Closet provides high school students with free formal wear so they can fully participate in milestone events like prom and homecoming.
These Kids are Cookin’ teaches cooking and nutrition skills to low-income 4th and 5th grade students in Title I-A schools.
Senior Caring delivers personal care items and holiday gifts to low-income seniors in assisted living and memory care.
Hats & More provides handmade hats, knit prosthetics and comfort shawls for cancer patients in infusion centers.
CENTRAL OREGON LOCAVORE
ABOUT US
Connecting Central Oregon with Local Food—All Year Long


Since 2009, Central Oregon Locavore Nonprofit has connected our community with the farmers and ranchers who feed us.
Our year-round indoor farmers market and five hands-on programs—like WWOLF, Small Farmer Support Program, and Meet Your Farmer Dinners—bring people closer to the source of their food.
When you shop at Locavore, you’re doing more than buying groceries: you’re supporting Central Oregon farms, strengthening our local economy, and helping ensure food security for our region.
Keep local farmers growing and ranchers going—no matter the season.
Shop Local. Eat Local. Support Local.





ABOUT US

FAMILY KITCHEN
ABOUT US
BASIC NEEDS
Family Kitchen was founded in 1986 by six women from Trinity Episcopal Church who felt the need to reach out to the community after the local mill shut down. They were concerned that, with the lack of local work, there would be a need for free meals. They were right.
Today, Family Kitchen serves meals every day of the year in downtown Bend and one meal a week in Sisters. In January 2024 we began providing meals six days a week in Redmond through partner agencies.
We distribute over 12,000 meals per month and have over 500 volunteers involved in our e orts.
ABOUT US


Furnish Hope is the only furniture bank east of the Cascades with the mission of turning empty spaces into homes and igniting hope for individuals and families rebuilding their lives in Central Oregon. Furnishing over 50 homes each month, we serve foster families, veterans, refugees and those transitioning from crisis. Through essential furnishings and community support, we create stability, restore dignity and foster a sense of belonging.
Together, we furnish hope and homes!
G R AN D M A’S H OU S E
ABOUT US


Young people with their babies are extremely vulnerable when they become homeless or escape abuse with no place to go. The immediate needs of safety, shelter, and food become enormous challenges. Such a rough beginning can be traumatizing and can have long-term e ects on these parents and the lives of their babies.
What they find at Grandma’s House is a home and support, a second family. During their time with us they learn life skills and nutrition, get pre- and post- natal care for themselves and their babies, and work toward self-su ciency.
A beginning that prepares young parents to build a future they want, and bridges the opportunity gap for the next generation.
We are the only home in our region serving the shelter needs of this vulnerable population, giving young parents the start they deserve and bridging opportunity for the next generation.
We are J Bar J Youth Services
S
ABOUT US
Heartwarmers is an all-volunteer organization that hosts weekly workshops to create free, handmade gifts for people in transition across Central Oregon. For more than 12 years, these gifts have been distributed through a network of over 60 partner non-profits, many of which are also featured in the Central Oregon Gives listings.
In addition to supporting the missions of our partner organizations, Heartwarmers provides meaningful opportunities for over 100 volunteers who joyfully gather each week to help those most in need within our community.
All donated funds are used exclusively to purchase materials for these gifts—ensuring that every dollar directly supports individuals and families in need.




F
HE AR TW A R M ER
Heartwarmers

BASIC NEEDS
The High Desert Food & Farm Alliance (HDFFA) builds a strong, resilient food system in Central Oregon. We support local farmers and ranchers, increase access to nutritious food for neighbors facing food insecurity, and educate our community about the value of local food.
These e orts create a ripple e ect: people have the healthy food they need, farmers and ranchers grow their businesses, and consumers engage in a thriving local food system.
Now more than ever, we need your support! Government funding is uncertain, but the need is growing. Your investment sustains our work ensuring access to healthy, locally grown food and helping our food producers thrive.
Together, we’re creating a stronger, more equitable food system that nourishes us all.
ABOUT US
Sisters Habitat for Humanity is part of a global, nonprofit housing organization that seeks to put love into action by building homes, communities, and hope. Sisters Habitat for Humanity is dedicated to eliminating substandard housing locally through constructing, rehabilitating, and preserving affordable homes; advocating for fair and just housing policies; and providing training and access to resources to help families improve their shelter conditions.
We build and repair homes to provide safe, stable and affordable homes in the greater Sisters community.
Since its founding, Sisters Habitat for Humanity has created more than 80 homes in Sisters to provide opportunities for households with incomes less than 80% Area Median Income to own a home. Our goal is to construct at least 30 affordable homes within the next three years. The stability inherent in homeownership is key to sustaining individual and family well-being.
ABOUT US
Promoting Opportunity for All



For 60 years Opportunity Foundation has been a cornerstone in our Central Oregon community empowering individuals with intellectual and developmental disabilities (IDD) to live, work, and thrive. What began as a small group of families determined to create more opportunities has grown into the only nonprofit in Central Oregon o ering a full range of services under one roof. When families turn to the Opportunity Foundation, they find more than a program, they find a partner. From employment support and residential services to skill-building, training, and community inclusion, we've built a continuum of care that helps people grow in confidence, independence, and belonging.
Whether in search of employment, independent living, social interaction, or personal growth, we provide personalized support so people with intellectual and developmental disabilities have the opportunity to reach their goals and make their dreams come true.

If you are interested in volunteering, seeking meaningful employment, or a local business interested in employing individuals with disabilities in the workplace, we would love to connect with you! Visit our website to get involved and to learn more about the wide range of services we provide throughout Central Oregon.



SISTERS HABITAT FOR HUMANITY
O PP O RT U NITY FOUNDATION O F

ABOUT US
RootedHomes provides environmentally sustainable and permanently a ordable homeownership opportunities for the people who make Central Oregon such an amazing place to live. These are the teachers, caregivers, and local workers who keep our communities thriving yet are often priced out of the very towns they serve.
For homeowner Denise Rowcroft, owning a home in Bend once felt impossible. “Absent the land trust, we would not have been able to own a house in Bend,” she shares. “It literally felt like we won the lottery.” RootedHomes helps families like the Rowcrofts-Sites put down lasting roots, living where they work, and creating a stable future.
RootedHomes is building over 100 sustainable, a ordable homes throughout Central Oregon in the next three years — from Redmond to Prineville and Madras. With your help, we can keep the heart of our community right here at home. Donate today to help us reach our $25,000 goal, which will be matched by a local family — doubling your impact!

S UPP O RTING AFGHAN FAMIL I E S INC .
ABOUT US – KEEPING OUR NATION’S PROMISES!



Supporting Afghan Families, a local 501c3 charity is led by Retired Army Colonel, Mark L. Rathburn, along with our board of community leaders, including an American with expertise beyond Kabul in Taliban controlled warzones. After serving multiple tours, Mark’s team has responded to the heart-wrenching evacuation of Kabul in August of 2021 leaving behind their Afghan Brothers-in-arms, and their families.
Our Vision is supporting Afghan families with immigration assistance because they stood by our service-members keeping them safe. Sadly, these families, approved through the Special Immigrant Visa (SIV) program are caught in limbo, sometimes months and years while awaiting final immigration approval. Monthly, we deliver food and life support to these families in hiding. They are hunted and in fear of not only their life, but the lives of their extended family.
Donations from YOU, are transferred to our in-country Afghan partners, directly to vetted waiting families. Many Afghan lives are saved by networking with other Afghan rescue organizations in collaboration with Congressional Representatives, State Department Immigration O ces, and Embassies.
As a 100% volunteer organization, we rely entirely on citizen participation!
With your donations, we have anonymous donors willing to match up to $2,000!
• $100 feeds a family of four for one month.
• $50 buys a phone card critical for internet and communication access
Become a warrior of the human spirit! Help us to save lives one Afghan family at a time.






THE GIV IN G P L AT E
ABOUT US
BASIC NEEDS
The Giving Plate operates four core hunger-relief programs: the Grocery Program, Kid’s Korner, Kid’s Korner Mobile Pantry, and Kids Korner Snack Packs. In 2024, we provided food to over 97,000 individuals, distributing over 986,000 pounds of food. Our Grocery Program allows families to access our new Community Store, where guests shop for free in an empowering, choice-based environment. Through Kid’s Korner, children joyfully select their own food in a kid-friendly space. We are committed to providing compassionate, dignified support because no one should feel shame for needing help. Your support not only fights hunger but also feeds hope, making a real di erence. Join us to ensure no one in our community goes hungry.




THE PEACEFUL PRESENCE PROJECT
ABOUT US
BASIC NEEDS
The Peaceful Presence Project reimagines and transforms the way communities talk about, plan for and experience the last stage of life. We support individuals and families with planning for serious illness and the end of life, provide in-person, bedside presence during the last months, weeks or days of life a death.
We envision a culture in which every community member receives equitable, compassionate support through the end of life. To date, we have delivered more than 900 hours of client services at no charge to the recipient. Our Compassion Funds make it possible for anyone in Central Oregon to receive this care.
Your generous donation will help ensure that No One Dies Alone in Central Oregon.

TH R IV E CENT R AL OREGO N
ABOUT US

Thrive Central Oregon's mission is to connect individual needs to community resources.
Thrive Central Oregon meets families and individuals - our neighbors - in public spaces to connect them with the assistance they are looking for. There are many resources in Central Oregon, but the and utilize a holistic, individual-led approach to services, and in doing sustainable and trauma-informed way
In 2024, Thrive assisted over 2,000 households in connecting to needed resources. From locating food banks to applying for Social health insurance, Thrive works to meet whatever need folks come to our services with. In the past 12 months, Thrive Community Outreach Advocates have helped 184 households move into sustainable housing!
Anyone can utilize Thrive services through one of our 15 weekly drop-in times, by email, or by phone We have drop-in locations across Central Oregon's 3 counties, and are free of charge
Show your support with our Thrive winter pom hat, yours with any donation of $50 or more!
100% of every donation goes into the Thrive Housing Fund, which supports those in our community working toward housing stability by providing application fees, rent, and deposit assistance





UNITED WAY OF CENTRAL OREGON
ABOUT US
Invest in United Way. Join us in nurturing hope, dignity, and opportunity—for everyone.
We all believe Central Oregon deserves a future where everyone can thrive. Yet here in Central Oregon, 1 in 3 households—about 30,000 families—struggle daily just to make ends meet.
You have the power to strengthen our community—you can turn your compassion into action. That’s why we’re here: to help you make it happen.
Everything we do depends on you—your support helps move thousands of children, families, and neighbors in Central Oregon from surviving to thriving. Here’s how your investment makes a di erence:
• Housing Stabilization
• Eviction Prevention
• Food Insecurity
• Homelessness
• Financial Stability
• Transportation
• Health and Hygiene
• Disaster Resilience

Every child deserves a safe, nurturing home. Every family deserves the security of meeting their basic needs. Every neighbor deserves the chance to be strong and resilient. Yet for too many in Central Oregon, these basic dignities remain out of reach.
• 34% of Central Oregonians are ALICE—Asset Limited, Income Constrained, Employed—meaning they don’t have enough income to cover their food, housing, transportation, healthcare, childcare, smartphone, and taxes.
• Oregon ranks worst in the nation in family homelessness—nearly 20 in 10,000 children live unsheltered in our state.
Central Oregonians like you have always stepped up—and so have we. Together, we’re showing up for our neighbors in Crook, Deschutes, and Je erson Counties with a commitment to fairness and opportunity. Here’s how United Way is making an impact:
Resilient Families Fund

Keeping families fed, housed and stable by providing immediate support for essential needs, like food, rent, utilities, eviction prevention, and emergency expenses.
Ride United
Opening doors to opportunity through free transportation to access work, education, food, housing, healthcare, and other essential services.
CARES – Community Access to Resources & Essential Supplies
Collection Drives and a Laundry Truck (coming soon) to meet urgent needs and restore dignity today while laying the foundation for lasting stability tomorrow.
Coalition to End Family Homelessness
Moving Oregon from worst to first in family homelessness by leading statewide partners to drive systemic change through policy and advocacy.
Disaster Resilience
Helping families and neighbors weather wildfires, winter storms, and other extreme events—through disaster relief and resilience resources.
Grantmaking
Supporting nonprofits that meet urgent needs by providing emergency food and shelter.
When our neighbors thrive, our entire community thrives. But right now, too many children go to bed hungry. Too many families are unsure how they'll make ends meet.
This is where you come in. Your gift matters. Your support fuels change. By investing in our community, you help move families from surviving to thriving. United is the Way we inspire action, care for our neighbors, and build a stronger, more connected Central Oregon.



HEALTH & ENVIRONMENT
MEET OUR LOCAL NON PROFITS
Around the Bend Farms Incorporated
Bend Bikes
Cascade Cannery
Central Oregon Veteran’s Ranch
Deschutes Land Trust
Diversability Inc.
Destination Rehab
Friends of Family Farmers
NAMI Central Oregon
AROUND THE BEND FARMS
ABOUT US
Lines for Life
Partner’s In Care Inc
Planned Parenthood Columbia Willamette
Shoot the Cancer Target Company
The Environmental Center
Project Happy Face
Upper Deschutes Watershed Council
Volunteers In Medicine
At Around the Bend Farms, our mission is to expand access to locally and sustainably grown healthy food, and share practical knowledge on healthy living and eating in the communities we support. Primarily, we build and operate compact urban farm solutions that help put more fresh local produce within reach of more people.
We work to build an all-inclusive urban agriculture society, and we intently strive to bridge communities and foster connections with the folks who will receive our fresh produce.
Our Farm-to-Warm Springs project emerged from recognition of the disconnect between our Bend community and the Native American population within Central Oregon. We collaborate directly with our Warm Springs neighbors to grow awareness and understanding of our cultures and communities. We work together to help achieve food sovereignty, and forge stable networks within our collective food system.



B EN D B I K E S
ABOUT US
Safer streets Stronger community
• Our mission is to make it safe and convenient for everyone to walk, ride, and roll to work, school, the st or just around town
• We believe Bend should have a complete, connected network of bike-friendly routes that serve every neighborhood
• The most vulnerable among us children, older adults, and those with fewer resources are at greater risk when our streets prioritize cars over people
• By pushing for safer, more accessible streets, we’re helping create a healthier, more sustainable Bend for everyone
• Every bike ride helps reduce pollution, ease congestion, and build community connections
Together, we’re working toward a Bend where biking is safe, practical, and joyful for all.
ABOUT US




Every jar holds a season: the brightness of summer berries, the tang of brined radish, the warmth of pickled peppers, and flavors captured at their peak to be shared long after harvest Cascades Cannery partners with local farms to purchase surplus and imperfect produce, preserving it into shelf-stable foods that nourish Central Oregon year-round. These goods are
regional food economy
Since launching this summer, we’ve rescued 3,650 pounds of local produce, preserving it into more than 2,500 jars. With your support, we can grow to 20,000 jars in 2026, rescuing 30,000 pounds of food from waste







Your

















C A S C A D E S CANNE R Y

C
ABOUT US
Help Veterans Find Community and Purpose—Right Here at the Ranch
COVR is a working ranch where camaraderie, nature, and hands-on projects help veterans find community. We’re a place for veterans looking for inspiration and healing, and for veterans who want to contribute and inspire others.
Your gift keeps the gates open—powering daily Ranch and hydroponic operations, site upkeep, and the sta who make our programs and events possible. This winter, we’re converting our garage into a community workshop: a space where veterans will both teach and learn, forge strong networks, find inspiration, and rediscover hope. Make a gift. Change a life.
Keep the greenhouse growing · Equip volunteer workdays · Fund peer-led activities · Maintain safe, welcoming grounds
ABOUT US
The Deschutes Land Trust conserves and cares for the lands and waters that sustain Central Oregon, so local communities and the natural world can flourish together for generations to come. The Land Trust is working to create a future where conservation and community care come together to protect, heal, and sustain the natural world around us.
At the Land Trust, we love Central Oregon and thrive in time spent outside exploring and caring for the land and waters of this amazing place with friends, family, and community. We are also passionate about conserving these places for today and tomorrow, and we take seriously our shared responsibility to care for the land now and for future generations.
Since 1995, the Land Trust has protected more than 18,700 acres in and around Central Oregon. This includes a network of local nature preserves that help local communities connect with the natural world close to home. Indian Ford Meadow Preserve and Whychus Canyon Preserve are just two examples. Each year, the Land Trust o ers more than 100 free walks, hikes, and outings, to explore these Preserves. We also o er a free, annual Nature Night lecture series and a variety of indoor and outdoor volunteer opportunities. Donate today: deschuteslandtrust.org
ABOUT US



We empower community connections for individuals with diverse abilities and their families. Our programs strengthen belonging for all.
The Happyning Hub (shown here)
Everyone belongs at The Happyning Hub! We host hands-on crafts, games, and community events that spark joy and friendship.
Youth Sibshops™
We host meet-up groups for 5 to 18-year-old siblings of people with disabilities/diversabilities. Every first Saturday, Siblings create art, foster friendships, and learn skills.
Diversability Village
Diversability Village connects you with trusted resources, from physical therapy to legal and financial planning and everything in between. We simplify the search so families can focus on what matters most — living fully. Visit DiversabilityVillage.org to begin your journey.
Join us in building a community where everyone belongs. Donate, volunteer, or connect today. Together, we create Connection!
www.deschuteslandtrust.org
info@deschuteslandtrust.org



D E SCHUT ES L A ND T RUS T

DESTINATION REHAB
ABOUT US
Our Mission Destination Rehab transforms the lives of adults with neurologic conditions through outdoor adventures in Central Oregon. Our services, such as personalized physical therapy, outdoor group support programs, and weekly fitness classes, promote health, independence, and community reintegration.
Your donation directly impacts the lives of Destination Rehab participants:
• $85 – One month of PEAK Fitness membership
• $150 – Comprehensive evaluation and onboarding for a new participant
• $300 – Six weeks of walking soccer
• $1,000 – A full summer of our Adventure Group program
7,300+ service hours annually!
"Rehab has changed my life. Seriously. I had a pretty big stroke almost 17 years ago, which still limits my mobility. I used to really enjoy being outdoors with my work as a geologist and for fun recreation. Since my stroke, it’s been a challenge to do pretty much anything outside except short walks on a smooth sidewalk. Traditional therapy works on “Activities of Daily Living (ADLs)” such as putting on a shirt and sitting up and down in a chair. I think of my ADLs at Destination Rehab as Actually Doing Life! Now I put on a shirt AND a life jacket and sit in a kayak in the beautiful alpine waters of Little Lava Lake! Now that is pretty cool- I am really living!"
- A Trailblazer Participant
ABOUT US



Friends of Family Farmers supports Oregon's small to mid-sized farmers and ranchers through programs and policies that protect, promote, and sustain sustainable local food systems across the state. We believe that when local farms thrive, so do the communities that depend on them.
For 20 years, we've been helping Oregon's independent farmers grow success through hands-on support, community building, and advocacy. Our Oregon Farm Link program helps new and expanding farmers find secure access to land and community resources. The Oregon Pasture Network supports ranchers raising animals on pasture and rangeland, providing education, community building and marketing tools to expand access to pasture-raised, humanely produced meat, dairy, and eggs. And through farmer-led advocacy, we protect Oregon’s farmland, ecosystems, and the livelihoods of those who feed us.
Central Oregon values fresh, local food, open landscapes, and strong community connectionsjust like we do. Supporting Friends of Family Farmers is a meaningful way to keep local food systems thriving, nourish ourselves & our neighbors, and sustain Oregon’s local food future.
ABOUT US

NAMI Central Oregon is a non-profit organization that provides support, education, and advocacy for people with mental illness and their loved ones in Deschutes, Crook, and Je erson Counties. NAMI stands for National Alliance on Mental Illness.
The Mission of NAMI Central Oregon is to improve the quality of life for persons living with mental health challenges and their families through engagement, support, education, and advocacy.
Serving Deschutes, Je erson, and Crook counties, our grassroots non-profit organization was built on a foundation of using lived experience to empower individuals, families and communities.




NAMI CENTRAL OREGON
FR IENDS O F F AMIL Y F ARM ER S

CENTRAL OREGON YOUTHLINE
ABOUT US
The Central Oregon YouthLine (COYL) is a teen-to-teen crisis line, supported by youth volunteers who deeply understand the challenges their peers face today. There are two COYL call centers in Central Oregon: in Bend and on the Warm Springs Reservation. We reach young people on the lines and through classroom programming in an area that is experiencing a youth mental health crisis. In 2023, 58% of all deaths of youth ages 10-17 were suicides. Deschutes County has the highest youth suicide rate in Oregon, as well as being 19% higher than the national average. Strengthening YouthLine’s financial standing in Central Oregon is crucial to meeting the needs of youth in the tri-county area, more specifically Bend, Redmond, Prineville, Sisters, Madras and LaPine. Central Oregon deserves a strong, local response—and your support ensures we’re here for every teen in need.
Lines for Life is an Oregon-based nonprofit dedicated to the prevention of substance abuse and suicide and the promotion of mental wellness. We deliver our core services with 24/7 crisis helplines, community prevention initiatives, advocacy, and training programs. YouthLine Youth volunteers complete over 65 hours of extensive training, enabling them to professionally and compassionately support teen peers who may be experiencing anything from a poor test score to a break-up to a mental health crisis. In 2024, YouthLine volunteers answered over 25,000 crisis calls, chats and texts; and served over 65,000 youth.
PARTNE R S I N C A R E
ABOUT US
HEALTH & ENVIRONMENT


Partners In Care has been serving Central Oregon for over 45 years as the region’s leading and most trusted nonprofit hospice, home health, and palliative care provider, redefining hope for our community since the beginning. In 1979, a group of volunteers created their own model of care for people who were terminally ill, based on the hospice philosophy of care that had been adopted in the United States just years earlier. The organization, first known as ‘Friends of Hospice’ evolved into what we now know as Partners In Care, and has been serving communities across Deschutes, Crook, Je erson, Upper Klamath, and Lake Counties for over 45 years.
As the most trusted provider of home health, palliative care, and hospice services in Central Oregon, we provide care to communities throughout Deschutes, Crook, and Je erson counties. Our largely mobile workforce of over 200 employees serves patients and their families in a 10,000 square mile area. Nearly 200 local volunteers work with Partners In Care in fundraising, resource coordination, and other areas of community support. As the name Partners In Care suggests, our multi-disciplinary team not only serves patients with life-limiting illness and families during a most di cult time, but it’s also a valuable partner with other community resources and organizations, coordinating compassionate care and meeting a broad spectrum of care needs for many population segments.
PLANNED PARENTHOOD COLUMBIA WILLAMETTE
ABOUT US

Planned Parenthood Columbia Willamette (PPCW) is the largest nonprofit sexual and reproductive health care organization in Oregon. Our mission is to provide, promote, and protect access to sexual and reproductive health care, regardless of the patient’s income level, insurance, immigration status, race, or sexual orientation.
Last year, our dedicated staff served a record 74,000+ patient visits at our eight health centers, providing birth control, STI testing and treatment, cervical cancer screening and treatment, abortion care, gender affirming care, vasectomies, and more. In addition to these services, PPCW’s Education & Outreach programs provide comprehensive sex education and resources for local schools, educators, and young people.
Donations to PPCW help us ensure that every person in our community has access to sexual and reproductive health care, no matter what.

Central Oregon Youthline (503) 244-5211
info@linesforlife.org
linesforlife.org



SHOOT THE CANCER TARGET COMPANY
ABOUT US
Shoot the Cancer Target Company is proud to call Central Oregon home and our mission is rooted in serving this community. Through our events, products, and partnerships, we provide a meaningful way for individuals and families to release the stress and emotions that often come with a cancer diagnosis, o ering a positive coping outlet during di cult times.
The majority of our proceeds stay local—supporting cancer centers, research, and patient programs throughout Central Oregon so contributions directly bring hope, healing, and vital resources to our neighbors a ected by cancer.

shootthecancer@gmail.com
THE ENVIRONMENTAL CENTER
ABOUT US
Over the last 35 years, The Environmental Center has grown to become a regional leader in environmental education, engagement, and climate action. Our work helps to shape sustainable communities that meet human needs equitably, live within our planet’s ecological limits and build a prosperous economy for all — without compromising the ability for future generations to do the same.
Our mission is to embed sustainability into daily life in Central Oregon. We do this through educational programs, meaningful partnerships, and by advocating for policies to advance a low-carbon, resilient future.




Shoot The Cancer Target Company

PROJECT HAPPY FACE
ABOUT US
Project Happy Face: Clear Skin, Bright Futures. Delivered Healthcare with Compassion
In Oregon’s rural counties, where access to specialized healthcare is scarce, Project Happy Face (PHF) is transforming lives one patient, one smile, one mile at a time. Founded by nationally recognized Dermatology PA Amy Snow, PHF is a nonprofit dedicated to bridging the divide between urban and rural healthcare systems by delivering expert dermatologic care directly to underserved communities.
ABOUT US
VO LU NT E E R S I N
PHF’s mobile outreach trailer travels to remote zip codes where skin cancer screenings and dermatology services are virtually nonexistent. Through its Screen to Save program, PHF provides free skin cancer screenings, catching life-threatening conditions early and saving lives in areas where patients might otherwise go years without seeing a specialist. To date, PHF has identified multiple melanomas through its mobile unit, directly saving lives by catching skin cancer before it became deadly.
Right now in Central without health insuranc and food, childcare, or medical care, untreated or life threatening illness, and overwhelming medical bills.

Right now in Central Oregon, thousands without health insurance choose between healthcare and food, childcare, or housing. Without access to medical care, untreated conditions could lead to severe or life threatening illness, visits to the emergency room and overwhelming medical bills.
Volunteers in Medicine is our successful, to this terrible dilemma.
What we do
Volunteers in Medicine is our successful, local solution to this terrible dilemma.
What we do
Our patients are low-income, working covered by the Oregon Health Plan and
Our patients are low-income, working adults not covered by the Oregon Health Plan and who cannot
Clear Skin, Bright Futures program, a confidence-building initiative that provides free acne treatments and skincare to high school students who have no access to dermatology. Medications are delivered directly to their schools, eliminating barriers like transportation and cost. But PHF’s approach goes deeper than skin. Students receiving care sign a contract to smile at strangers and respond to four reflective essay questions, fostering civility, empathy, and self-worth. They graduate not only with clearer skin, but with a renewed sense of confidence and a commitment to give back.
We treat people by partnering with St. pro-bono specialists, and nearly 2,000 doctors, nurses and community members 20 years.
We treat people by partnering with St. Charles, local pro-bono specialists, and nearly 2,000 volunteer doctors, nurses and community members over the last 20 years.
It’s special. We are neighbors taking ca e of neighbors.
Tony’s story
It’s special. We are neighbors taking care of neighbors.
Tony’s story
Tony is a dishwasher at a local taco shop who began feeling dizzy until one day he fainted at work. When he awoke, his co-worker said this reminded him of diabetes. They drove straight to the emergency room, where Tony was tested. The co-worker was right: Tony had diabetes.
PHF’s model is rooted in mentorship and community-building. Teens are taught that receiving care is just the beginning, they’re encouraged to pay it forward once they’ve launched their careers. This philosophy plants seeds of civic responsibility and


Tony is a dishwasher at a local taco shop who began feeling day he fainted at work. When he awoke, his co-worker said him of diabetes. They drove straight to the emergency room, was tested. The co-worker was right: Tony had diabetes.
Now, with a large medical bill from the emergency room diagnosis, Tony was facing a major question. How would health problem and provide for his family?
Now, with a large medical bill from the emergency room and a new diagnosis, Tony was facing a major question. How would he pay for this health problem and provide for his family?
But the nurse told Tony about VIM. He got a referral to our seen quickly We provided glucose monitoring, education and the medication Tony needs to stay healthy and keep
But the nurse told Tony about VIM. He got a referral to our clinic and was seen quickly We provided glucose monitoring, education about nutrition, and the medication Tony needs to stay healthy and keep working.
“I don’t know what I would have done without VIM,” said Tony “I would probably have gotten sicker, with more complications. It could have spiraled out of control. It’s scary to think about ”
entire communities. The mobile unit is more than a trailer, it’s a lifeline, a safe space for teens, and a symbol of hope.
The outcomes
The outcomes
In our 20 years, we’ve:
In our 20 years, we’ve:
• Treated 16,000 patients
• Treated 16,000 patients
As part of this year’s local nonprofit donation campaign, Project Happy Face invites the community to support its mission. Donations will go directly to the patients who need medications and to fuel the mobile unit that delivers care across rural counties. Every dollar helps provide life-saving screenings, medical-grade treatments, and mentorship to youth who are ready to shine.

“I don’t know what I would have done without VIM,” said Tony “I would probably have gotten sicker, with more complications. It could have spiraled out of control. It’s scary to think about.”
• Provided 111,000 patient visits
• Provided 111,000 patient visits
• Racked up 114,000 volunteer hours
Change lives with a gift today! ABOUT US
• Racked up 114,000 volunteer hours


• Provided $150 million+ in medical care and community benefit
• Provided $150 million+ in medical care and community benefit
Change lives with a gift today!
Project Happy Face isn’t just treating skin, its building futures, fostering civility, and saving lives. With your support, we can continue to reach the zip codes that need us most and ensure that no teenager with acne is left behind because of where they live.





Project Happy Face

ABOUT US
Right now in Central Oregon, thousands of people without health insurance choose between healthcare and food, childcare, or housing. Without access to medical care, untreated conditions could lead to severe or life threatening illness, visits to the emergency room and overwhelming medical bills.
Volunteers in Medicine is our successful, local solution to this terrible dilemma.
What we do

VO LU NTEE R S I N M E DI CIN E
Our patients are low-income, working adults not covered by the Oregon Health Plan and who cannot otherwise a ord insurance.
VO LU NTEE R S IN MED I CIN E
We treat people by partnering with St. Charles, local pro-bono specialists, and nearly 2,000 volunteer doctors, nurses and community members over the last 20 years. It’s special. We are neighbors taking care of neighbors.
ABOUT US
In our 20 years, we’ve:
• Treated over 16,000 patients
• Provided 121,000 patient visits
• Racked up 123,000 volunteer hours
Right now in Central Oregon, thousands of people without health insurance choose between healthcare and food, childcare, or housing. Without access to medical care, untreated conditions could lead to severe or life threatening illness, visits to the emergency room and overwhelming medical bills.
Right now in Central Oregon, thousands of people without health insurance choose between healthcare and food, childcare, or housing. Without medical care, untreated conditions could or life threatening illness, visits to the eme and overwhelming medical bills.
Volunteers in Medicine is our successful, to this terrible dilemma.
• Provided more $212 million in medical care and community benefit Change lives with a gift today!
What we do
Healthcare at a Crossroads: Letter from the Executive Director
Volunteers in Medicine is our successful, local solution to this terrible dilemma.
Dear Friends and Neighbors,
What we do
Our patients are low-income, working covered by the Oregon Health Plan and
Our patients are low-income, working adults not covered by the Oregon Health Plan and who cannot
At Volunteers in Medicine, Clinic of the Cascades (VIM Cascades), we believe that healthcare is a fundamental human right. For over two decades, our clinic has been a lifeline for hardworking members of our Central Oregon community who, despite their many contributions, find themselves without insurance or access to a ordable medical care.
We treat people by partnering with St. Charles, local pro-bono specialists, and nearly 2,000 volunteer doctors, nurses and community members over the last 20 years.

We treat people by partnering with St. pro-bono specialists, and nearly 2,000 doctors, nurses and community members 20 years.
It’s special. We are neighbors taking ca e of neighbors.
Tony’s story
It’s special. We are neighbors taking care of neighbors.
Tony’s story


Our patients are the backbone of this region: construction workers, hospitality sta , small business owners, artists, home healthcare providers, and so many others who keep our economy and community thriving. They deserve quality care, and thanks to the dedication of our clinical volunteers and pro-bono medical partners, we provide it. Since 2004, we’ve served over 16,000 patients, delivered $212 million in healthcare value and community benefit, and distribute over $2.5 million in life-saving medications annually from our chartable pharmacy, the only one in Oregon east of the Cascades. We do all of this through a model built on compassion and community.
Tony is a dishwasher at a local taco shop who began feeling dizzy until one day he fainted at work. When he awoke, his co-worker said this reminded him of diabetes. They drove straight to the emergency room, where Tony was tested. The co-worker was right: Tony had diabetes.
The healthcare landscape in America is at a crossroads. The A ordable Care Act’s subsidies are set to expire this December, leading to 200% increases in premiums for individuals and businesses, leaving many unable to a ord insurance. Also, recent legislation means over 250,000 Oregonians could lose Medicaid coverage in the future, with ripple e ects straining hospitals and clinics statewide. Here in Central Oregon, we’re preparing for an influx of patients who may soon have nowhere else to turn.
Now, with a large medical bill from the emergency room and a new diagnosis, Tony was facing a major question. How would he pay for this health problem and provide for his family?
How You Can Help

Tony is a dishwasher at a local taco shop who began feeling day he fainted at work. When he awoke, his co-worker said him of diabetes. They drove straight to the emergency room, was tested. The co-worker was right: Tony had diabetes.
Now, with a large medical bill from the emergency room diagnosis, Tony was facing a major question. How would health problem and provide for his family?
But the nurse told Tony about VIM. He got a referral to our seen quickly We provided glucose monitoring, education and the medication Tony needs to stay healthy and keep
But the nurse told Tony about VIM. He got a referral to our clinic and was seen quickly We provided glucose monitoring, education about nutrition, and the medication Tony needs to stay healthy and keep working.
“I don’t know what I would have done without VIM,” said Tony “I would probably have gotten sicker, with more complications. It could have spiraled out of control. It’s scary to think about ”
This isn’t just a policy issue, it’s a human one. When people delay care because of cost, manageable conditions become emergencies. When clinics and hospitals close or waitlists grow, entire communities su er. VIM Cascades exists to bridge these issues, but we can’t do it alone.
“I don’t know what I would have done without VIM,” said Tony “I would probably have gotten sicker, with more complications. It could have spiraled out of control. It’s scary to think about.”
The outcomes
The
outcomes
In our 20 years, we’ve:
In our 20 years, we’ve:
• Treated 16,000 patients
• Treated 16,000 patients
• Provided 111,000 patient visits


• Give Generously – Every dollar helps us provide care for those who need it most. Your donation ensures prescriptions are filled, chronic conditions are managed and reduces burdens on our community health system.
• Provided 111,000 patient visits
• Racked up 114,000 volunteer hours
• Racked up 114,000 volunteer hours
• Volunteer Your Time – Whether you’re a medical professional or a community member with a passion for service, your skills can make a di erence.
• Provided $150 million+ in medical care and community benefit
• Provided $150 million+ in medical care and community benefit
Change lives with a gift today!
Change lives with a gift today!
VIM Cascades was founded in 2001 by a group of visionaries who refused to accept that hardworking people should go without care because they did not have insurance. Today, we carry that same determination. But as needs grow, so must our resources. If you believe, as we do, that healthcare should be accessible to all—please act now. Donate via our Central Oregon Gives page, volunteer, or otherwise champion our cause. Let’s ensure no one in Central Oregon has to choose between their health and other basic needs
With gratitude and hope,
Kat Mastrangelo Executive Director





